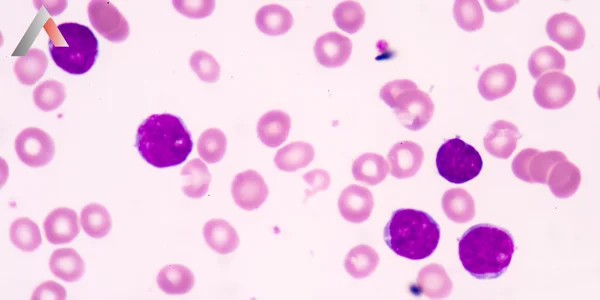
Akut_Lenfoblastik_L__semi_Nedir_dc43477f.webp

Akut Lenfoblastik Lösemi (ALL), kemik iliğinde başlayan ve kan ile vücudun diğer bölgelerine hızla yayılabilen bir kanser türüdür. Genellikle çocuklarda görülmekle birlikte yetişkinlerde de ortaya çıkabilir. Lösemi, beyaz kan hücrelerinin kontrolsüz bir şekilde çoğalmasıyla karakterizedir. Normalde, vücudumuz enfeksiyonlarla savaşmak için beyaz kan hücreleri üretir. ALL'de ise kemik iliği, çok sayıda olgunlaşmamış beyaz kan hücresi (blast) üretir. Bu blast hücreleri, normal kan hücrelerinin işlevlerini yerine getiremez ve enfeksiyonlarla savaşmada etkili değildir. Ayrıca, blast hücrelerinin sayısındaki artış, kırmızı kan hücreleri ve trombositlerin üretimini baskılayarak anemi ve kanamaya neden olabilir.
Akut Lenfoblastik Lösemi (ALL), lenfoblast adı verilen olgunlaşmamış beyaz kan hücrelerinin kontrolsüz bir şekilde çoğaldığı bir kanser türüdür. Bu anormal hücreler kemik iliğinde birikerek normal kan hücrelerinin üretimini engeller. ALL, hızlı ilerleyen bir hastalık olduğu için "akut" olarak adlandırılır. Çocukluk çağı kanserlerinin en sık görülen türlerinden biridir ve çoğunlukla 2-5 yaşları arasında teşhis edilir. Yetişkinlerde ise daha nadir görülür.
ALL'nin belirtileri, hastalığın evresine ve lösemi hücrelerinin vücudun hangi bölgelerine yayıldığına bağlı olarak değişebilir. En sık görülen belirtiler şunlardır:
ALL'nin kesin nedeni bilinmemektedir. Ancak, bazı genetik ve çevresel faktörlerin hastalık riskini artırabileceği düşünülmektedir. Bu faktörler arasında şunlar yer alır:
ALL tanısı, fizik muayene, kan testleri ve kemik iliği biyopsisi ile konulur.
ALL tedavisi, hastalığın evresine, hastanın yaşına ve genel sağlık durumuna göre değişir. Tedavinin temel amacı, lösemi hücrelerini yok etmek, normal kan hücrelerinin üretimini geri kazandırmak ve hastalığın tekrarlamasını önlemektir. ALL tedavisinde kullanılan başlıca yöntemler şunlardır:
ALL, genellikle aşağıdaki evrelere göre sınıflandırılır:
ALL tedavisi genellikle uzun ve zorlu bir süreçtir. Tedavi süresi, hastalığın evresine, hastanın yaşına ve genel sağlık durumuna göre değişebilir. Genellikle 2-3 yıl sürer. Tedavi süreci boyunca, hastalar düzenli olarak doktor kontrolüne gitmeli ve kan testleri yaptırmalıdır. Tedavinin yan etkileri de dikkatle izlenmeli ve gerekli önlemler alınmalıdır.
ALL'nin iyileşme şansı, hastalığın evresine, hastanın yaşına ve genel sağlık durumuna bağlı olarak değişir. Çocuklarda ALL'nin iyileşme şansı oldukça yüksektir. Yetişkinlerde ise iyileşme şansı daha düşüktür. Erken teşhis ve doğru tedavi ile ALL'nin kontrol altına alınması ve hastaların uzun ve sağlıklı bir yaşam sürmeleri mümkündür.
ALL tanısı alan hastaların yaşam süresi, hastalığın evresine, tedaviye yanıtına ve hastanın genel sağlık durumuna bağlı olarak değişir. Çocuklarda ALL'nin 5 yıllık sağkalım oranı %90'ın üzerindedir. Yetişkinlerde ise bu oran daha düşüktür.
ALL tedavisi gören hastaların dengeli ve sağlıklı beslenmeleri çok önemlidir. Tedavinin yan etkilerini azaltmak ve vücudun direncini artırmak için yeterli kalori ve protein alınması önemlidir. Tedavi sırasında iştah kaybı, bulantı, kusma ve ağız yaraları gibi yan etkiler görülebilir. Bu nedenle, beslenme planı hastanın ihtiyaçlarına göre düzenlenmelidir.
A Life Sağlık Grubu olarak, Akut Lenfoblastik Lösemi (ALL) tanısı alan hastalarımıza ve ailelerine destek olmak için buradayız. Uzman hematologlarımız, onkologlarımız ve diğer sağlık profesyonellerimiz, hastalarımızın tedavi sürecini en konforlu şekilde geçirmeleri için özveriyle çalışmaktadır. Tedavi planlaması, hastanın yaşı, genel sağlık durumu, hastalığın evresi ve genetik özellikleri gibi faktörler göz önünde bulundurularak kişiye özel olarak yapılır. Amacımız, hastalarımızın yaşam kalitelerini artırmak ve iyileşme şanslarını en üst düzeye çıkarmaktır.
Unutmayın, erken teşhis ve doğru tedavi ile ALL'nin üstesinden gelmek mümkündür.
Not: Bu makalede sunulan bilgiler genel bilgilendirme amaçlıdır ve tıbbi tavsiye yerine geçmez. Herhangi bir sağlık sorununuz varsa, lütfen bir doktora danışın.

Lütfen size ulaşabilmek için aşağıdaki alanları doldurunuz
7/24 tüm soru ve sorunlarınız için buradayız.